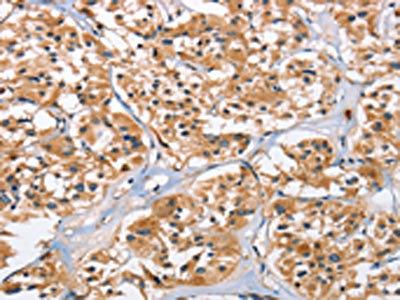

EIF4EBP2 Antibody
-
中文名稱:EIF4EBP2兔多克隆抗體
-
貨號(hào):CSB-PA940544
-
規(guī)格:¥1100
-
圖片:
-
The image on the left is immunohistochemistry of paraffin-embedded Human liver cancer tissue using CSB-PA940544(EIF4EBP2 Antibody) at dilution 1/40, on the right is treated with fusion protein. (Original magnification: ×200)
-
The image on the left is immunohistochemistry of paraffin-embedded Human thyroid cancer tissue using CSB-PA940544(EIF4EBP2 Antibody) at dilution 1/40, on the right is treated with fusion protein. (Original magnification: ×200)
-
-
其他:
產(chǎn)品詳情
-
Uniprot No.:
-
基因名:EIF4EBP2
-
別名:4E-BP2 antibody; 4EBP2 antibody; 4EBP2_HUMAN antibody; eIF4E binding protein 2 antibody; eIF4E-binding protein 2 antibody; Eif4ebp2 antibody; Eukaryotic translation initiation factor 4E binding protein 1 antibody; Eukaryotic translation initiation factor 4E-binding protein 2 antibody; PHASII antibody; phosphorylated; heat and acid stable regulated by insulin protein II antibody
-
宿主:Rabbit
-
反應(yīng)種屬:Human,Mouse
-
免疫原:Fusion protein of Human EIF4EBP2
-
免疫原種屬:Homo sapiens (Human)
-
標(biāo)記方式:Non-conjugated
-
抗體亞型:IgG
-
純化方式:Antigen affinity purification
-
濃度:It differs from different batches. Please contact us to confirm it.
-
保存緩沖液:-20°C, pH7.4 PBS, 0.05% NaN3, 40% Glycerol
-
產(chǎn)品提供形式:Liquid
-
應(yīng)用范圍:ELISA,IHC
-
推薦稀釋比:
Application Recommended Dilution ELISA 1:2000-1:5000 IHC 1:50-1:200 -
Protocols:
-
儲(chǔ)存條件:Upon receipt, store at -20°C or -80°C. Avoid repeated freeze.
-
貨期:Basically, we can dispatch the products out in 1-3 working days after receiving your orders. Delivery time maybe differs from different purchasing way or location, please kindly consult your local distributors for specific delivery time.
-
用途:For Research Use Only. Not for use in diagnostic or therapeutic procedures.
相關(guān)產(chǎn)品
靶點(diǎn)詳情
-
功能:Repressor of translation initiation involved in synaptic plasticity, learning and memory formation. Regulates EIF4E activity by preventing its assembly into the eIF4F complex: hypophosphorylated form of EIF4EBP2 competes with EIF4G1/EIF4G3 and strongly binds to EIF4E, leading to repress translation. In contrast, hyperphosphorylated form dissociates from EIF4E, allowing interaction between EIF4G1/EIF4G3 and EIF4E, leading to initiation of translation. EIF4EBP2 is enriched in brain and acts as a regulator of synapse activity and neuronal stem cell renewal via its ability to repress translation initiation. Mediates the regulation of protein translation by hormones, growth factors and other stimuli that signal through the MAP kinase and mTORC1 pathways.
-
基因功能參考文獻(xiàn):
- molecular dynamics simulations to investigate both the folded and unfolded states of 4E-BP2 under different phosphorylation states of T37 and T46 PMID: 28068774
- isoaspartate formation repair modulates the interaction of deamidated 4E-BP2 with mTORC1 in brain PMID: 20424163
- PHAS-II, but not PHAS-III, contributes to the control of protein synthesis by insulin PMID: 14507920
-
蛋白家族:EIF4E-binding protein family
-
數(shù)據(jù)庫鏈接:
Most popular with customers
-
-
YWHAB Recombinant Monoclonal Antibody
Applications: ELISA, WB, IHC, IF, FC
Species Reactivity: Human, Mouse, Rat
-
Phospho-YAP1 (S127) Recombinant Monoclonal Antibody
Applications: ELISA, WB, IHC
Species Reactivity: Human
-
-
-
-
-